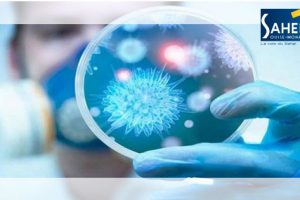

أعلنت وزارة الصحّة أنها استلمت الهبة التي تقدمت بها الجمعية التونسية للأدوية الجنيسة ومخابر SAIPH ومخابر IPS SAÏD ومخابر MEDIS، مشيرة الى أنّها تتمثّل في كميات...
Archive - أبريل 2020
ظهرت مؤخرا شائعات مفادها أن فيروس كورونا الجديد، يمكن أن يبقى في جسم الشخص المصاب لسنوات، وأن علاجه ربما يستمر مدى الحياة، مثل التهاب الكبد “ب”،...
نشرت وكالة الأنباء الفرنسية الرسمية، رسما بيانيا، حول ترتيب الدول العربية من حيث انتشار وباء كورونا المستجد، خلال الفترة الممتدة من 1 مارس إلى 1 أفريل 2020. و...
تعرضت مدرسة ابتدائية بعمادة سيدي خليفة التابعة لمعتمدية بوفيشة من ولاية سوسة ليلة البارحة إلى عملية تخريب و تكسير و القيام بكتابة ألفاظ بذيئة على جدران الأقسام...
اعلنت الجامعة التونسية لكرة القدم مساء اليوم الجمعة إنهاء موسم 100 فريق في الرابطات الجهوية وقرار صعود 3 أندية اضافية الى جانب تخصيص نظام مسابقات خاص بـ20 ناد...
عبر عميد الصيادلة الشاذلي الفندري عن استنكاره واستغرابه من المعلومات التي نشرها المجلس الوطني لهيئة مساعدي الصيادلة بتونس دراسة لبروفيسور في الصيدلة في جامعة...
دعت بلدية حمام سوسة من خلال بلاغ أصدرته الجمعة المواطنين إلى الاحتفاظ بالحيوانات و عدم إهمالها بالطريق العام ، حيث لوحظ في الفترة الأخيرة تواجد عدد كبير من...
أعلنت وزارة الصحة مساء أمس الجمعة تخصيص الموقع الالكتروني www.med.tn للاستشارات الطبيّة المتعلّقة بفيروس كورونا الجديد COVID-19. ويأتي ذلك في إطار اتفاقيّة...
أكدّ المدير الجهوي للصحّة بسوسة سامي الرقيق، تسجيل 4 حالات جديدة بفيروس كورونا إثر صدور نتائج 60 تحليلا مخبريا مساء الجمعة. وأكدّ الرقيق أنّ الحالات المسجلة عن...

Recent Comments